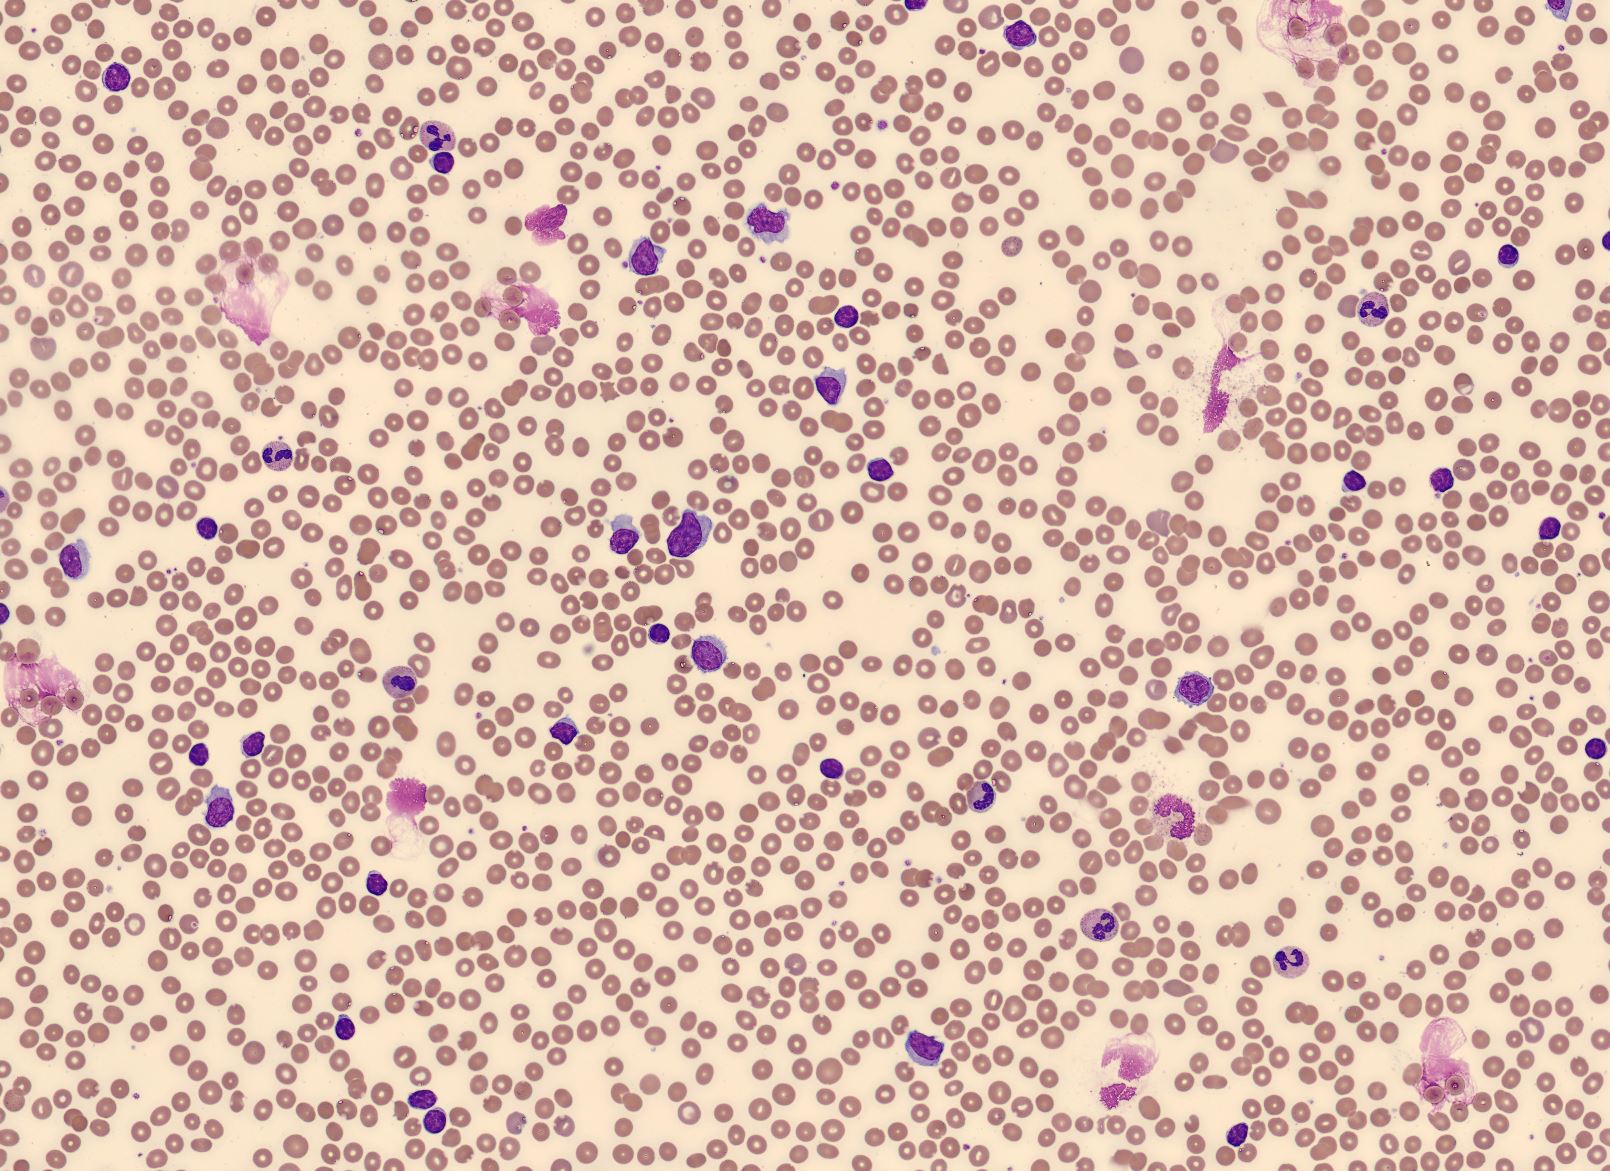
RBC Overview CellaVision Monthly Cell Challenge January 2026

Monthly Cell Challenge #01 / 2026

Spot the Difference
A 72-year-old male was referred to the hematology clinic due to progressive fatigue, unintentional weight loss, night sweats, and abdominal discomfort over the past several months. The patient also reported early satiety. Clinical examination revealed marked splenomegaly, while lymphadenopathy was absent or minimal. There was no previous history of hematologic disease.
CBC results:
| Test | Result | Units |
|---|---|---|
| WBC | 80 | x109/L |
| HGB | 9.5 | g/L |
| MCV | 87 | fL |
| PLT | 93 | x109/L |
Blood smear analysis pre-classification on CellaVision DC-1
| WBC Differential | % | x109/L |
|---|---|---|
| Neutrophils | 11.9 | 9.5 |
| Lymphocytes | 88.1 | 70.4 |

The peripheral blood smear demonstrated two distinct lymphoid cell populations. One population consisted of small, mature-appearing lymphocytes with round nuclei, densely clumped chromatin, and scant pale cytoplasm. The second population was composed of larger lymphoid cells with round to slightly oval nuclei, more open and moderately condensed chromatin, and a single prominent nucleolus. These cells showed a moderate amount of cytoplasm, often forming a wider cytoplasmic rim compared with the smaller lymphocytes. The larger cells appeared relatively uniform in size and morphology and accounted for approximately half of the circulating lymphoid cells.
Flow cytometry results: CD19+, CD20 (bright)+, CD22+, CD79a+, surface Ig (bright)+, FMC7+, CD23−, CD10−, CD5−/dim, CD43−, CD45 (bright)+, CD38+, CD34−, TdT−
Diagnosis:
The patient was diagnosed with Prolymphocytic leukemia (PLL).
Discussion:
Prolymphocytic leukemia (PLL) is a rare and aggressive mature lymphoid leukemia, most often affecting elderly patients and typically presenting with marked leukocytosis and splenomegaly [1]. Morphologically, the disease is characterized by a significant proportion of large lymphoid cells with moderately condensed chromatin and a single prominent nucleolus. According to the criteria described by Bain, these cells are larger than normal lymphocytes and show more open chromatin and increased cytoplasmic volume, features that help distinguish them from the small mature lymphocytes seen in chronic lymphocytic leukemia [2].
The presence of two distinct lymphoid populations in the peripheral blood, one composed of small mature lymphocytes and the other of larger lymphoid cells with prominent nucleoli, indicates heterogeneity within the lymphoid population. Careful morphological evaluation of the peripheral blood smear is therefore essential, as it allows recognition of these differences and helps guide targeted immunophenotypic analysis [2].
In the WHO 5th Edition classification (2024), B-cell prolymphocytic leukemia is no longer recognized as a distinct diagnostic entity [1]. Cases previously classified as B-PLL are now interpreted within a broader disease context, most commonly representing prolymphocytic progression of chronic lymphocytic leukemia or falling within other mature B-cell neoplasms, such as splenic B-cell lymphoma/leukemia with prominent nucleoli. Although the terminology has changed, the identification of a characteristic prolymphocytic morphological pattern in peripheral blood remains clinically important and should trigger thorough correlation with immunophenotypic, cytogenetic, and clinical findings to achieve accurate classification [1,2].
This case underscores the continued importance of peripheral blood morphology in identifying abnormal lymphoid populations. By carefully examining the blood smear, differences in cell size, nuclear appearance, and chromatin pattern can be recognized, helping guide further diagnostic testing. In cases with mixed lymphoid populations, digital cell morphology using CellaVision systems supports this process by facilitating visualization, separation, and accurate counting of distinct cell populations, for example through side-by-side comparison and the use of dedicated cell classes for abnormal, atypical, reactive or variant lymphoid cells.
Reference:
[1] WHO Classification of Tumours Editorial Board. WHO Classification of Haematolymphoid Tumours. 5th ed. Lyon: International Agency for Research on Cancer; 2024.
[2] Bain BJ. Blood Cells: A Practical Guide. 6th ed. Oxford: Wiley Blackwell; 2020.